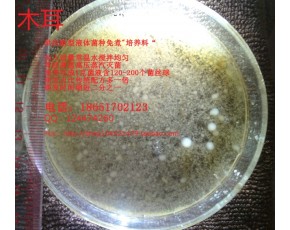

供應(yīng)液體菌種天然培養(yǎng)料 發(fā)酵罐千分之一接種量 成熟時(shí)間: 平菇 秀珍菇 杏鮑菇 木耳 猴頭菇 蟲草
白靈菇 48小時(shí);金針菇 茶樹菇 靈芝 72小時(shí) ;香菇 海鮮菇 蟹味菇 白玉菇 120小時(shí)
雅康生物液體菌種免煮培養(yǎng)料特點(diǎn):
一、 本店所經(jīng)營食用菌液體菌種專用培養(yǎng)基,各種優(yōu)質(zhì)原料經(jīng)過嚴(yán)格篩選、測(cè)量、洗滌、調(diào)整比例
、蒸煮、精細(xì)過濾提純、干燥、研磨成極細(xì)的可溶性粉末狀,嚴(yán)格的生產(chǎn)管理制度保證各批次的活性指
標(biāo)穩(wěn)定,耐儲(chǔ)存,使用方便,培養(yǎng)成熟后活力強(qiáng),萌發(fā)快,菌絲球單位密度極高,是理想的現(xiàn)代液體菌
種培養(yǎng)基。基質(zhì)為干燥粉末,滅菌器前按比例對(duì)入適量的冷水,充分?jǐn)嚢枞芙獾綗o結(jié)塊,再經(jīng)普通醫(yī)用
單層紗布過濾后即可裝罐滅菌,滅菌后有少量沉淀為正常狀態(tài),培養(yǎng)成熟后菌液澄澈,恒溫?zé)o光放置96
小時(shí)后對(duì)活性無影響。
二、 使用本產(chǎn)品所生產(chǎn)的液體菌液,菌絲活性比傳統(tǒng)的菌液活性要高,萌發(fā)快,萌發(fā)點(diǎn)多,抗污染
能力強(qiáng)等優(yōu)點(diǎn)
1、 每毫升菌液達(dá)到120-200個(gè)菌絲球
2、 菌絲萌發(fā)時(shí)間比目前普通培養(yǎng)液縮短二分之一
3、 菌絲封面時(shí)間比目前普通培養(yǎng)液縮短二分之一
4、 同等接種量,發(fā)酵罐培養(yǎng)時(shí)間比普通培養(yǎng)液快2-4天
5、 菌絲水洗后烘干重每升4-5克
6、 在出菇瓶/袋接種后,由于菌絲吃料封面快,污染也會(huì)減少,發(fā)菌滿袋時(shí)間比傳統(tǒng)培養(yǎng)液快2-7
天不等
三角瓶制作:
1、使用容量10升不銹鋼圓桶作配液桶,盛入5升常溫自來水。
2、如果客戶訂購的免煮培養(yǎng)料一包可配5升培養(yǎng)液,則加入一包該培養(yǎng)料到水中,使用攪拌棒等器具對(duì)
培養(yǎng)液進(jìn)行攪拌,直到攪拌到無顆粒即可。
3、溶解后的培養(yǎng)液,從配液桶倒進(jìn)三角瓶,大約占三角瓶容量的三分之二,水中大顆粒的固體物需要用
50目尼龍網(wǎng)紗做一次過濾,預(yù)防日后發(fā)生堵塞。
4、三角瓶灌裝好培養(yǎng)液后,封上蓋子,在2小時(shí)內(nèi)進(jìn)行高壓蒸汽滅菌,溫度121度,滅菌時(shí)間20-30分鐘
不等,壓力降到零后出鍋,在干凈環(huán)境自然冷卻。
5、待三角瓶冷卻到25度即可進(jìn)行接種。一個(gè)三角瓶接入1cm*1cm PDA菌種即可,接種后使用旋轉(zhuǎn)搖床,
轉(zhuǎn)速200次/分鐘、恒溫25度、避光、不間斷旋轉(zhuǎn)培養(yǎng),培養(yǎng)5-8天(視乎品種而定)即可接種到發(fā)酵罐。
發(fā)酵罐制作(200L):
1、使用容量250升不銹鋼圓桶作配液桶,盛入180-200升常溫自來水。
2、如果客戶訂購的免煮培養(yǎng)料一包可配100升培養(yǎng)液,則加入兩包該培養(yǎng)料到水中,使用攪拌器、潛水
泵等器具對(duì)培養(yǎng)液進(jìn)行攪拌,直到攪拌到無顆粒即可(約1-10分鐘不等)。
3、溶解好的培養(yǎng)液,使用潛水泵從配液桶抽到發(fā)酵罐里面,水泵出水口需要包裹單層50目尼龍網(wǎng)紗,過
濾水中大顆粒的固體物,預(yù)防日后發(fā)生堵塞。
4、200升的發(fā)酵罐灌裝好培養(yǎng)液后,在2小時(shí)內(nèi)進(jìn)行高壓蒸汽滅菌,溫度121度,滅菌時(shí)間40-70分鐘不等
5、待發(fā)酵罐冷卻到25度即可進(jìn)行接種。一個(gè)發(fā)酵罐接種入一個(gè)三角瓶(300ml-600ml)液體原種后進(jìn)行23
-25度的恒溫培養(yǎng),連續(xù)供氣培養(yǎng)5-8(視乎品種而定)天為最佳使用時(shí)間。
6、接入出菇袋/瓶時(shí),接種噴嘴噴出的液體壓力需達(dá)到1.5公斤,以保證菌種的均勻度縮短萌發(fā)時(shí)間。




124474260

 食用菌產(chǎn)品庫
食用菌產(chǎn)品庫